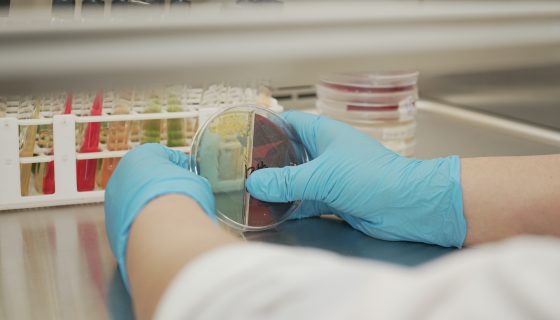

Administración de Empresas
Licenciado/a en Administración de Empresas
Administración de Empresas (Modalidad Dual)
Licenciado/a en Administración de Empresas
UTT Salvador Allende
Administración de Infraestructura y Plataformas Tecnológicas
Tecnólogo/a Superior en Administración de Infraestructura y Plataformas Tecnológicas
UTT Salvador Allende
Automatización e Instrumentación
Técnico/a Superior en Automatización e Instrumentación
Contabilidad y Auditoría
Licenciado/a en Contabilidad y Auditoría
Educación Básica
Licenciada/o en Ciencias de la Educación Básica
Educación Inicial
Licenciado/a en Ciencias de la Educación Inicial
Emprendimiento e Innovación
Licenciado/a en Emprendimiento e Innovación
Género y Desarrollo
Licenciado/a en Género y Desarrollo
UTT Salvador Allende
Instalaciones de Redes Eléctricas
Técnico/a Superior en Instalaciones de Redes Eléctricas
Orientación Familiar
Licenciado/a en Orientación Familiar
Pedagogía de la Actividad Física y Deporte
Licenciado/a en Pedagogía de la Actividad Física y Deporte
Pedagogía de la Historia y las Ciencias Sociales
Licenciado/a en Pedagogía de la Historia y las Ciencias Sociales
Pedagogía de la Lengua y la Literatura
Licenciado/a en Pedagogía de la Lengua y Literatura
Pedagogía de las Artes y Humanidades
Licenciado/a en Pedagogía de la Filosofía
Pedagogía de las Ciencias Experimentales: Matemáticas y Física
Licenciado/a en Pedagogía de las Matemáticas y la Física
Pedagogía de las Ciencias Experimentales: Química y Biología
Licenciado/a en Pedagogía de la Química y la Biología
Pedagogía de los Idiomas Nacionales y Extranjeros
Licenciado/a en Pedagogía del Idioma Inglés